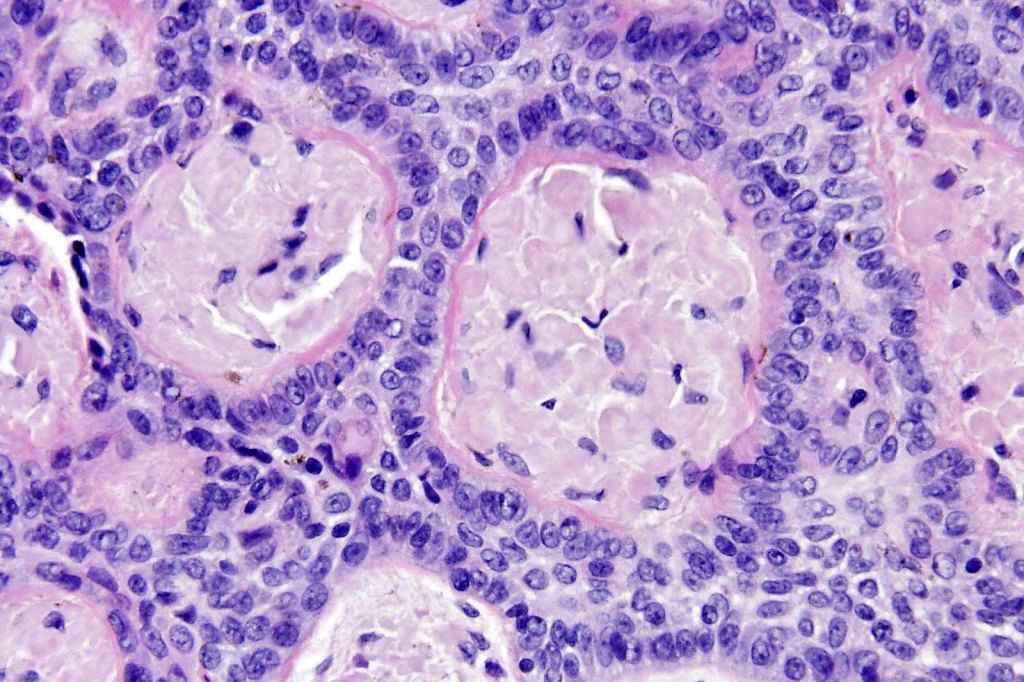

Clinical features
•Rare tumor which may represent a variant of BCC or a fenestrated trichoblastoma
•Predominantly seen in the middle-aged or elderly
•F>M
•Presents mostly on the lower trunk (lumbosacral region) & thighs, less often head & neck
•Flesh colored or pink polypoid, nodule or plaque
•Occasionally pigmented
•Association with prior radiotherapy
•Possible syndromic association- gastrointestinal tumors

Histological features
•Multifocal origin from epidermis
•Anastomosing basaloid, narrow epithelial strands associated with a prominent fibrous (sometimes myxoid) stroma
•Ductal differentiation likely represents entrapped ducts rather than spread along the eccrine ducts
•Peripheral palisade
•Round to oval vesicular nuclei with small nucleoli
•Mitoses very scanty or absent
•Retraction artifact variably present
•Hair germs sometimes present
•Amyloid may be seen
•Occasional cysts
•Rarely associated with typical BCC
•CK20 +ve Merkel cells almost invariably present
.Androgen receptor present in up to 75% of cases

Leave a comment